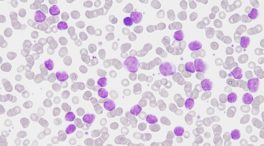

El vínculo tan especial de Karlos Arguiñano con su hermana Lionaz: «Le doné médula ósea»
Su hermana mayor sufrió leucemia hace más de quince años y en 2021 tuvo una recaída en la que le ayudó el chef

Su hermana mayor sufrió leucemia hace más de quince años y en 2021 tuvo una recaída en la que le ayudó el chef

La combinación de dos fármacos orales ha demostrado ser eficaz en modelos celulares y animales

El laboratorio ha anunciado un acuerdo de licencia exclusiva con la empresa china para comercializar su tratamiento

Las terapias CAR-T suponen una nueva esperanza y son «lo mejor que existen hoy en día» según Fran Barreto

El hallazgo abre nuevas vías para el desarrollo de tratamientos contra esta patología

Muchos subtipos son menos conocidos por ser menos prevalentes, pero no por ello menos agresivos o con mejor pronóstico

Berlusconi, líder de la formación Fuerza Italia, ingresó el miércoles en el hospital San Rafael de Milán

Durante el ensayo clínico, realizado entre 2019 y 2022, de los 60 pacientes un 53% tuvo algún grado de remisión y un 30% mostraron una remisión completa

La Sala Primera anula un auto de la juez del ‘caso Erial’ y ampara a Francisco Grau, presunto testaferro de Zaplana, por vulnerar sus derechos fundamentales

Este descubrimiento es relevante porque cuando el efecto de esta molécula es demasiado fuerte o prolongado se convierte en un arma de doble filo

Alyssa fue diagnosticada en mayo de 2021 con una leucemia linfoblástica aguda de células T y se sometió sin éxito a quimioterapia y un trasplante de médula ósea
Este tipo de cáncer de la sangre es el tipo de leucemia más frecuente en el mundo occidental, con una incidencia en torno a los 5 casos por cada 100.000 habitantes

El cáncer infantil desarrolla 1.000 casos nuevos cada año, no se puede prevenir ni detectar a tiempo porque el conocimiento es insuficiente

Alumnos de todas las edades recibieron entre aplausos al pequeño de seis años que venció a la leucemia después de tres duros años de lucha

“Mis dos hijos pasaron de jugar juntos a sentarse en una habitación fría del hospital”, ha explicado la madre en el post

El entrenador del club de primera división ha enviado un mensaje de tranquilidad al equipo y a los aficionados

El cáncer infantil, a pesar de ser una enfermedad rara, cada año es diagnosticado en cerca de 1.400 niños con edades comprendidas entre los o y los 18 años.

Un grupo de científicos del Campus Clínic-UB del Instituto de Investigación contra la leucemia Josep Carreras han detectado un marcador biológico que da un mejor pronóstico de supervivencia en pacientes con uno de los tipos de leucemia infantil más grave.

El presidente del Gobierno, Pedro Sánchez, baraja el 14 de abril para convocar elecciones generales. El exiministro Eduardo Zaplana ha recibido este lunes por la mañana el alta del hospital La Fe de Valencia. WhatsApp se ha convertido en el canal por el que se comparten más bulos de salud.

El presidente del Gobierno, Pedro Sánchez, baraja el 14 de abril para convocar elecciones generales. El exiministro Eduardo Zaplana ha recibido este lunes por la mañana el alta del hospital La Fe de Valencia. WhatsApp se ha convertido en el canal por el que se comparten más bulos de salud.

La Sociedad Española de Hematología y Hemoterapia avala que el expresidente de la Generalitat Valenciana y exministro Eduardo Zaplana siga ingresado en el hospital o bajo control médico domiciliario dado el riesgo vital grave del paciente.

El exministro y expresidente de la Generalitat Eduardo Zaplana permanece ingresado en el Hospital La Fe de Valencia, adonde fue trasladado el pasado martes desde el centro penitenciario de Picassent para realizar una revisión programada. Fuentes sanitarias han confirmado que Zaplana sigue ingresado en el centro hospitalario, pero no han precisado más detalles sobre su estado de salud.

Por undécimo año la Fundación Aladina organiza su mercadillo solidario cuyos fondos irán destinados 100% a programas de apoyo emocional para niños con cáncer

Por tercer año consecutivo la Asociación Española de Fisioterapia Oncológica (AEFO) organiza The Day Of Life –Día de la Vida–, un evento de ocio familiar para recaudar fondos con el fin de ofrecer una mejor calidad de vida a niños con cáncer, así como evitar las secuelas que aparecen después de años de haber superado la enfermedad y que impiden el desarrollo de los niños.

Un equipo de 51 investigadores del Idibaps (Institut d’investigacions biomèdiques August Pi i Sunyer) ha descifrado el funcionamiento del genoma de la leucemia linfática crónica, el tipo más frecuente de esta enfermedad, por el que la médula ósea produce un número demasiado elevado de linfocitos.

El productor y guionista neoyorquino Steven Bochco, recordado por series como ‘Hill Street Blues’,’L.A. Law’ y ‘NYPD Blue’, ha fallecido este lunes a los 74 años, según han informado medios locales.

Pablo Ráez, el chico malagueño de 20 años que levantó la voz contra el silencio sobre la leucemia, falleció el domingo rodeado de sus familiares, cuando asumió su destino y optó por morir entre sus seres queridos.

En el memorable comienzo del primer capítulo de The Knick (que recrea la vida de un hospital en Nueva York en 1900), el doctor Thackery habla en el funeral de su mentor, que acaba de suicidarse tras el enésimo fracaso en su intento por practicar con éxito una cesárea. Ante una audiencia deprimida de familiares y amigos dolientes, el cirujano pronuncia una inesperada oda al progreso: “Vivimos en un tiempo de infinitas posibilidades, se ha aprendido más sobre el tratamiento del cuerpo humano en los últimos cinco años que en los últimos 500. Algunos túneles se caerán, algunas presas serán anegadas. Nuestros corazones se pararán, pero nosotros, los humanos, lucharemos por unos latidos más en la batalla antes de rendirnos”.

Después de recibir la vacuna, todos los pacientes permanecieron sin la enfermedad durante al menos un año. Pero 12 de ellos continuaron en remisión durante una media de cuatro años y nueve meses. “Esto supone el 70% de los pacientes que participaron. Estamos muy emocionados con estos resultados preliminares, ya que necesitamos mejores terapias para curar la leucemia”, indica Jacalyn Rosenblatt, autora principal del estudio. La quimioterapia elimina las células cancerosas de esta enfermedad, pero la mayoría de los pacientes suelen sufrir una recaída con una versión más resistente del cáncer. Según los investigadores, la tasa de supervivencia a cinco años es de sólo el 34%. Gracias a esta vacuna, que estimula de forma personalizada en cada paciente una fuerte respuesta inmune contra la leucemia, este porcentaje podría verse incrementado muy pronto.

Los científicos han descubierto que cuando dentro de un gen específico de la célula ―el precursor de leucocitos― surgen mutaciones, las células madre se vuelven más sensibles a las reacciones inflamatorias. Como resultado de esto se activa la enzima ADAR1, conocida por poder editar el ARN let-7, reemplazando la adenosina ―el componente principal de los nucleótidos A― por la inosina (un nucleósido intermediario de las rutas de síntesis de los ácidos nucléicos) y alterar su composición. Al identificar el mecanismo de funcionamiento de la enzima ADAR1, los científicos han desarrollado un método que permite detener la degeneración de las células.

La causa: el edificio se construyó cerca de tres fábricas de productos químicos. De acuerdo con informaciones publicados por la cadena estatal CCTV, pruebas realizadas en la Escuela de Idiomas Extranjeros de Changzhou han detectado en el suelo y el aire niveles peligrosos de toxinas. Según los informes, las clases comenzaron antes de la finalización de un estudio sobre el impacto ambiental de las fábricas en el agua subterránea y el suelo de la zona. Tras la indignación pública, el ministerio de Medio Ambiente anunció una inspección urgente en la escuela.

“Hemos luchado. Teníamos el objetivo a la vista. Estamos agradecidos por un tiempo juntos increíblemente bueno. El amor perdura”, anunció en un mensaje la Fundación Westerwelle en su página web. Westerwelle, que encabezó el Partido Democrático Libre (FDP) y entre 2009 y 2013, fue jefe de la diplomacia alemana en la pasada legislatura (2009-2013) y ‘número dos’ del Gobierno de la canciller Angela Merkel. El político abandonó totalmente la vida pública tras anunciar su enfermedad, en junio de 2014.